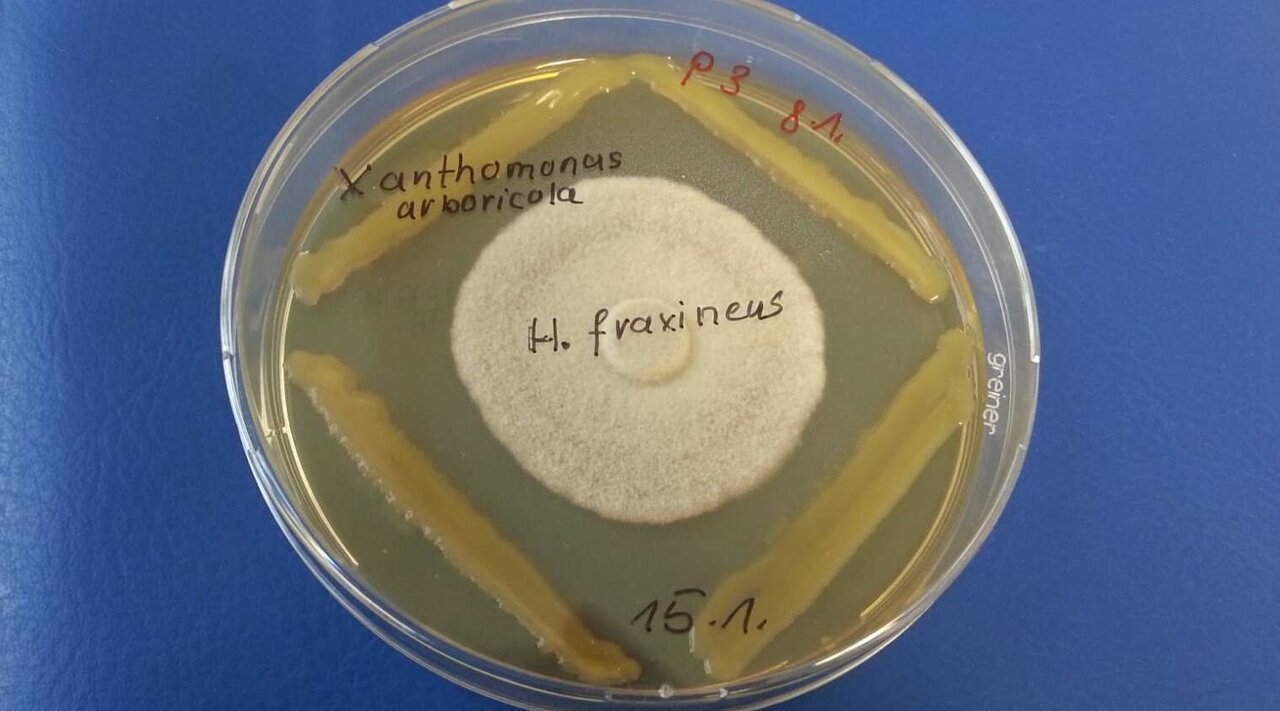

Institut für
FG Forstgenetik
Projekt
Entwicklung eines biologischen Kontrollsystems zur Regulierung des Erregers des Eschentriebsterbens Hymenoscyphus fraxineus
Entwicklung eines biologischen Kontrollsystems zur Regulierung des Erregers des Eschentriebsterbens Hymenoscyphus fraxineus
Entwicklung eines biologischen Kontrollsystems zur Regulierung des Erregers des Eschentriebsterbens Hymenoscyphus fraxineus
Hintergrund und Zielsetzung
Das durch Hymenoscyphus fraxineus verursachte Eschentriebsterben hat sich seit Mitte der 1990er Jahre europaweit ausgebreitet und stellt durch das Absterben ganzer Bestände die forstliche Zukunft der Esche in Frage. Die biologische Kontrolle der Erkrankung durch geeignete mikrobielle Antagonisten, die den Schadorganismus direkt bekämpfen und/oder durch Konkurrenz unterdrücken, ist eine aussichtsreiche Option zur Eindämmung des Eschentriebsterbens und kann eine synergistisch wirkende Ergänzung zur Züchtung resistenter Genotypen darstellen.
Im Projekt soll ein biologisches Kontrollsystem zur Bekämpfung des Schaderregers auf der Grundlage epi- und endophytischer Isolate, die sich an der Esche stabil etablieren können, entwickelt werden. Erfolgversprechende Bakterien und Pilze werden in einem mehrstufigen Verfahren charakterisiert und evaluiert. Hierfür werden zunächst die Mikrobiome resistenter und anfälliger Eschen über drei sich ergänzende Sequenzierungsansätze (NGS von Markergenen) analysiert; und Taxa bzw. Stämme mit antagonistischem Potenzial identifiziert. Parallel hierzu wird eine Vielzahl von Bakterien- und Pilzstämmen kultiviert und klassifiziert (MALDI-TOF-MS). Basierend auf einer vergleichenden Analyse der Mikrobiome resistenter und anfälliger Eschen (kulturabhängig und kulturunabhängig) werden potentielle Antagonisten (Isolate und mikrobielle Konsortien) ausgewählt. Nach dem Screening des antagonistischen Potentials in vitro (über Ko-Kultivierung), wird ihre Wirkung in Gewächshausversuchen mit Eschenjungpflanzen (in planta) geprüft und die Grundlagen ihrer antagonistischen Eigenschaften charakterisiert.
Die angestrebte Bereitstellung antagonistisch wirksamer, an die Esche angepasster Mikroorganismen soll entscheidend zur Eindämmung des Eschentriebsterbens beitragen. In der nachfolgenden Anwendung sollen die mikrobiellen Präparate in Samenplantagen zur Entwicklung resistenter Pflanzen eingesetzt werden.
Vorgehensweise
Im Projekt soll ein biologisches Kontrollsystem zur Bekämpfung des Schaderregers auf der Grundlage epi- und endophytischer Isolate, die sich an der Esche stabil etablieren können, entwickelt werden. Erfolgversprechende Bakterien und Pilze werden in einem mehrstufigen Verfahren charakterisiert und evaluiert. Hierfür werden zunächst die Mikrobiome resistenter und anfälliger Eschen über drei sich ergänzende Sequenzierungsansätze (NGS von Markergenen) analysiert; und Taxa bzw. Stämme mit antagonistischem Potenzial identifiziert. Parallel hierzu wird eine Vielzahl von Bakterien- und Pilzstämmen kultiviert und klassifiziert (MALDI-TOF-MS). Basierend auf einer vergleichenden Analyse der Mikrobiome resistenter und anfälliger Eschen (kulturabhängig und kulturunabhängig) werden potentielle Antagonisten (Isolate und mikrobielle Konsortien) ausgewählt. Nach dem Screening des antagonistischen Potentials in vitro (über Ko-Kultivierung), wird ihre Wirkung in Gewächshausversuchen mit Eschenjungpflanzen (in planta) geprüft und die Grundlagen ihrer antagonistischen Eigenschaften charakterisiert.
Die angestrebte Bereitstellung antagonistisch wirksamer, an die Esche angepasster Mikroorganismen soll entscheidend zur Eindämmung des Eschentriebsterbens beitragen. In der nachfolgenden Anwendung sollen die mikrobiellen Präparate in Samenplantagen zur Entwicklung resistenter Pflanzen eingesetzt werden.
Ergebnisse
Die Mikrobiomanalyse toleranter und anfälliger Eschen über Amplikon-Sequenzierung zeigte eine hohe Diversität an Bakterien und Pilzen. Zusammen mit der Klassifizierung von über 4000 Isolaten durch MALDI-TOF MS Analyse ergab sich ein vollständiges Bild über die Unterschiede zwischen toleranten und anfälligen Bäumen. Durch eine differentielle Abundanzanalyse basierend auf beiden Methoden konnte eine Reihe von taxonomischen Gruppen gefunden werden, die spezifisch für tolerante Eschen sind. Besonders Isolate der Phylotypes Luteimonas fraxinea und Aureimonas „altamirensis“ wurden als aussichtsreiche Kandidaten für die Bekämpfung von H. fraxineus auf Basis der Kolonisierungsresistenz ermittelt. Hinzu kam eine Auswahl von Isolaten, die bei der Ko-Kultivierung antagonistische Aktivität gezeigt hatten (Teilvorhaben 1). Für die Durchführung der Pflanzentests wurden insgesamt 37 bakterielle und pilzliche Isolate ausgewählt, die in vitro antagonistische Effekte gezeigt hatten oder Taxa mit erhöhter Abundanz in toleranten Eschen repräsentierten. In zwei von drei Untersuchungsjahren mit H. fraxineus-Befallsdruck konnte durch Sprossinokulation mit den Stämmen Bacillus velezensis A4P130, Luteimonas fraxinea D4P002 und C4P040a, Aureimonas „altamirensis“ C2P003 und Paenibacillus „lautus“ B3P038 eine signifikante Verbesserung des Gesundheitszustandes der Testpflanzen festgestellt werden. Nachhaltig positive Effekte über drei Jahre ergaben sich für die Stämme A4P130, D4P002 und C2P003. Parallel zur Sprossinokulation wurde die Inokulation stratifizierter Samen getestet, die sich jedoch nicht als praktikabel erwies. Die Analyse des Mikrobioms in zwei Pflanzentests zeigte eine signifikante Veränderung der bakteriellen Gemeinschaften nach Inokulation mit P. „lautus“ B3P038, L. fraxinea D4P002 und A. „altermirensis“ C2P003 sowie mit dem Konsortium aus D4P002 und C2P003. Das lässt vermuten, dass auch Stämme ohne direkte antagonistische Aktivität über Kolonisierungs¬resistenz oder indirekt über die Veränderung des Eschen-Mikrobioms zur Pathogen-Abwehr beitragen. Die funktionelle Genomanalyse von L. fraxinea D4P002 ergab zahlreiche Eigenschaften, die mit der Fähigkeit zur Pathogenabwehr bzw. der Ausprägung einer Kolonisierungs-resistenz in Verbindung stehen. Zusammenfassend konnten in Zusammenarbeit mit Teilvorhaben 1 vier Bakterienstämme und ein Konsortium als Kandidaten für die biologische Kontrolle des Eschentriebsterbens isoliert, charakterisiert und bereitgestellt werden.
Thünen-Beteiligte
Beteiligte externe Thünen-Partner
- Leibniz-Zentrum für Agrarlandschaftsforschung (ZALF) e.V.
(Müncheberg, Deutschland)
Geldgeber
-
Fachagentur Nachwachsende Rohstoffe e.V. (FNR)
(national, öffentlich)
Zeitraum
6.2017 - 6.2022
Weitere Projektdaten
Förderprogramm: FNR
Projektstatus:
abgeschlossen



